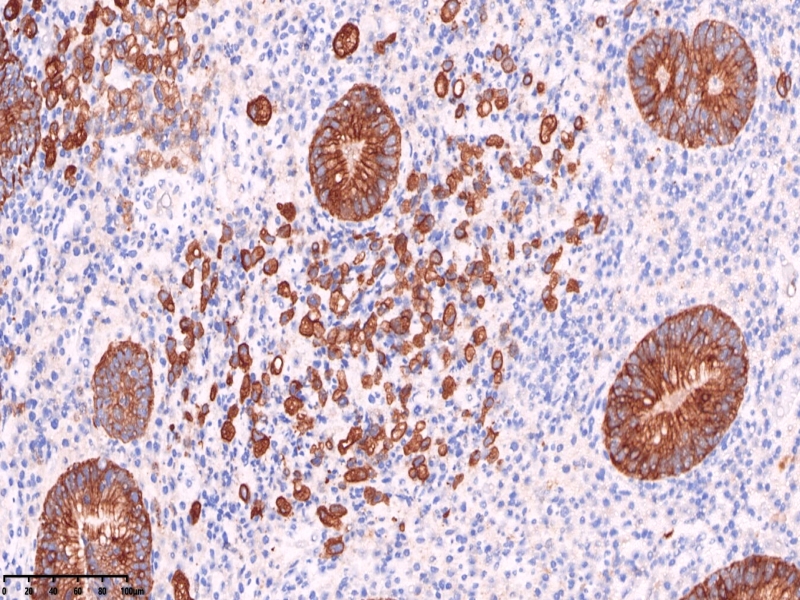

我的博文
胃脘部疼痛6天
2025-10-13 14:22
阅读(20)
评论(0)
分类:胃
女、38岁254620,胃脘部疼痛6天,胃镜检查可见胃体小弯可见一2*2厘米深溃疡。活检数块。
镜下可见胃活检组织,炎症背景明显,小凹及固有腺体结构大致正常,但是其中一块组织内固有层内可见小片状弥漫分布的上皮样异型细胞,组织细胞?浆细胞?溃疡直径大于1厘米,应首先除外肿瘤。





免疫组化常规片内异型上皮细胞更显著。核偏位的异型上皮细胞,胞浆似泡沫样,但是与组织细胞不同,组织细胞核位于中央,与印戒细胞也不太一样,印戒细胞胞浆内为明显的粘液空泡。









免疫组化标记后异型上皮细胞更显著。
CKpan

ck7

这一段时间胃癌病例较集中。
本文允许在互联网范围内转载,使用时请注明作者姓名、作品名称及作品来源。
上一篇:食管-贲门-胃体肿物。
下一篇:切白片
我要评论
共0条评论